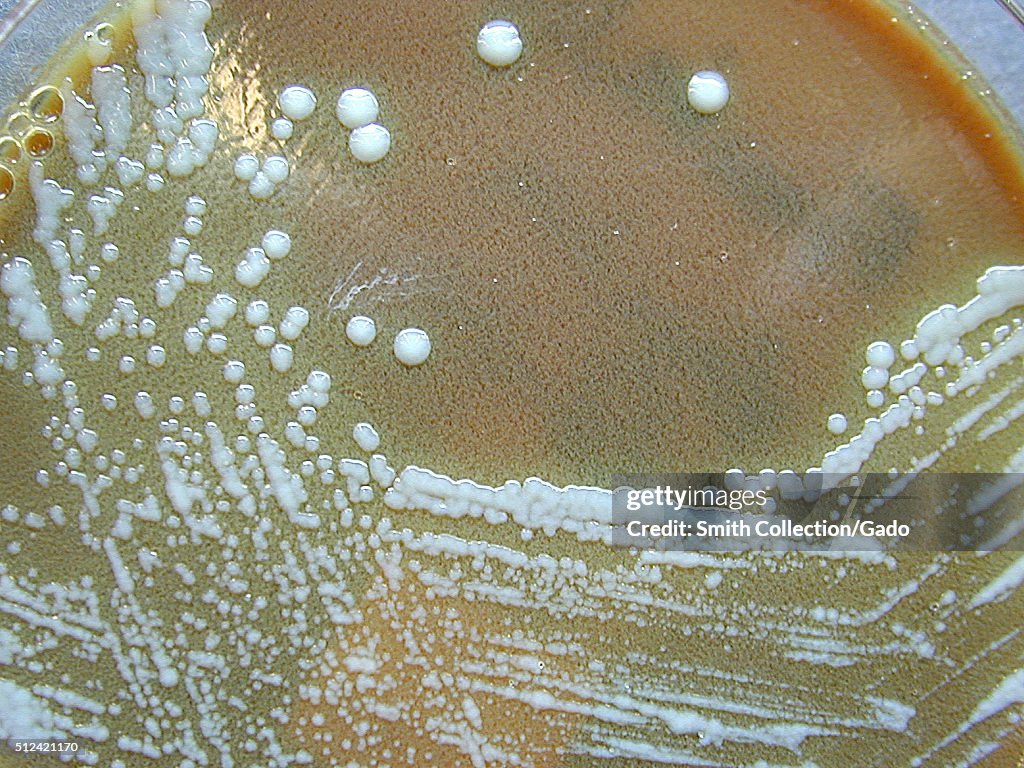
Francisella Tularensis

Francisella Tularensis
Francisella tularensis, Colonization on Cysteine Heart Agar after 72 hours. F. tularensis, Colony Characteristics when grown on Cysteine Heart Agar, colonies 2-4 mm, smooth, entire, greenish-white, butyrous with opalescent sheen at 48-72hrs. Image courtesy CDC/Courtesy of Larry Stauffer, Oregon State Public Health Laboratory, 2002. (Photo by Smith Collection/Gado/Getty Images).
ACHETER UNE LICENCE
Comment puis-je utiliser cette image ?
385,00 €
EUR
Getty ImagesFrancisella Tularensis, Photo d'actualité
Francisella Tularensis Obtenez des photos d'actualité haute résolution de qualité sur Getty ImagesProduct #:512421170

475€175€
Getty Images
In stockRemarque : les images illustrant des événements historiques peuvent contenir des thèmes, ou avoir des descriptions, qui ne reflètent pas la compréhension actuelle. Elles sont fournies dans un contexte historique. En savoir plus.
INFORMATIONS
Restrictions :
Contactez votre agence locale pour toute utilisation commerciale ou promotionnelle.
Crédits :
Editorial - n° :
512421170
Collection :
Archive Photos
Date de création :
1 janvier 2002
Date de chargement :
Type de licence :
Infos autorisations :
Autorisation non disponible. Plus d'infos
Source :
Archive Photos
Référence :
66027final.jpg
Taille max. de fichier :
5200 x 3898 px (44,03 x 33,00 cm) - 300 dpi - 5 MB